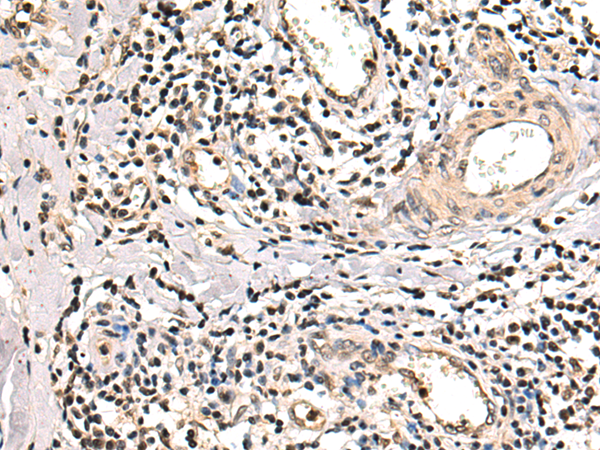
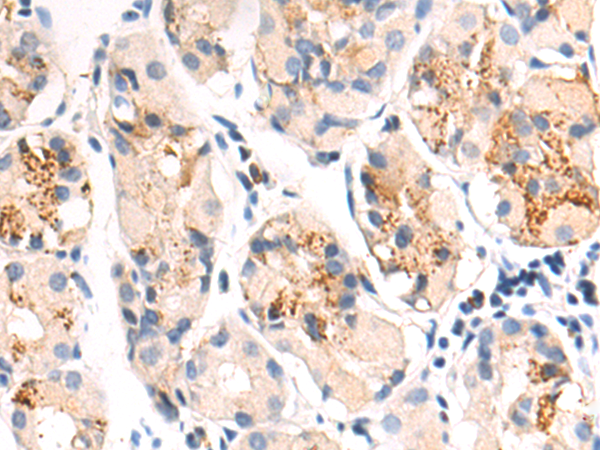

-
分类: 科研抗体货号: P00547别名: MUC-20应用: IHC反应种属: Human
-
分类: 科研抗体货号: P00563别名: NGFB; HSAN5; Beta-NGF应用: IHC反应种属: Human, Mouse, Rat
-
分类: 科研抗体货号: P00545别名: MPF; SMRP应用: IHC反应种属: Human
-
分类: 科研抗体货号: P00621别名: EDR, HB-1, Mar2, MEF3L, Mart2, RGAG3应用: WB反应种属: Human
-
分类: 科研抗体货号: P00543别名: DUP; FAP4; MRP1应用: WB,IHC反应种属: Human, Mouse
-
分类: 科研抗体货号: P00620别名: OI6; OI12; PEDF; EPC-1; PIG35应用: WB,IHC反应种属: Human, Mouse
-
分类: 科研抗体货号: P00538别名: MM28, MMP25, MMP-28, EPILYSIN应用: WB反应种属: Human, Mouse
-
分类: 科研抗体货号: P00619别名: IMF1; KOGS; IBGC4; JTK12; PDGFR; PENTT; CD140B; PDGFR1; PDGFR-1应用: WB,IHC反应种属: Human, Mouse, Rat
-
分类: 科研抗体货号: P00641别名:应用: WB反应种属: Human
-
分类: 科研抗体货号: P00613别名: H731应用: WB,IHC反应种属: Human, Mouse, Rat

鄂公网安备42018502007531号
鄂公网安备42018502007531号

